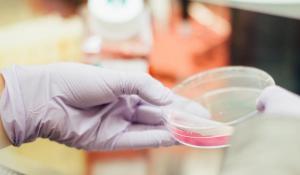

Genetic engineering (GE), or genetic modification, is the process of manipulating an organism’s DNA to display specific traits. Gene splicing introduces new genetic material into an organism’s DNA, resulting in a genetically modified organism (GMO). More recently developed methodologies of genetic engineering include gene-editing. This technology allows scientists to target specific traits and either remove or rearrange them. In most cases, none of these modifications would be possible under natural circumstances and are only obtained through intensive research and experimentation in a laboratory.
The Problem with Genetic Engineering: It's Poorly Regulated and Harmful to Environmental Health
Biased Research and Lack of Government Regulation
Uncertainties around the safety of genetically modified organisms (GMOs) and related herbicides can be attributed to lax regulation by the FDA, USDA, and EPA and the lack of unbiased scientific research on the long-term human and environmental health impacts. For example, Monsanto marketed glyphosate (the chemical found in RoundUp that is the most frequently used herbicide with GMOs) as safe, but in recent years, the World Health Organization found that glyphosate is a probable carcinogen and a jury ordered Monsanto to pay $289 million to a school groundskeeper who got terminal cancer after using RoundUp.
Much of the current research around GMOs has been conducted by major companies in the industry, calling into question the legitimacy of their findings and possible conflict of interest. Many studies conducted by scientists not affiliated with the industrial agricultural complex have called into question the safety of consuming GE crops.
Further unbiased research regarding health and safety issues is needed. And, the government entities responsible for the wellbeing of farmers, consumers, and the environment must pursue regulations to protect these stakeholders.
Engineered to Withstand Chemicals that Negatively Affect Ecosystems, Farm Workers, and Consumers
The most common GMOs are crops developed to be resistant to herbicides, such as glyphosate, 2,4-D, and/or dicamaba, and engineered with the pesticide Bt to protect against pests (the plant itself contains the Bt toxin). Since the crops are engineered to resist the effects of pesticides and herbicides, most commonly glyphosate, these chemicals are sprayed freely and extensively on the farm, negatively impacting surrounding communities and destroying ecosystems.
These effects are seen in the decline of key pollinator species, including honeybees and monarch butterflies.
Farm soils are degraded from monocropping, a method required in GE crop growing. In turn, poor soil health requires farmers to rely on additional synthetic inputs, including nitrogen fertilizers, which further perpetuates dependence on fossil fuels and pollutes waterways.
Excessive use of pesticides and herbicides in conjunction with GE crops has led to superweeds and pests that have developed resistance to the most commonly used chemicals, forcing farmers to turn to much more toxic chemicals. In turn, these chemicals pollute and poison the soil, waterways, and human that come into contact with them. Both glyphosate and 2,4-D—herbicides used extensively on GE crops—have been deemed probable carcinogens by the World Health Organization.
The Solution to Genetic Engineering: Regenerative Agriculture and Sustainable Farming Practices
GMOs have no place in a sustainable agricultural system.
In order to sustain our soil and food supply, we must move to a regenerative system of agriculture, with its basis in the principles of organic agriculture. This means moving away from destructive chemical inputs such as synthetic pesticides and fertilizers and moving towards systems that compliment the natural biology in the soils and surrounding environment, including rotation of diverse cropos, use of on-farm mulching materials, composting, and many others.
Green America actively engages with members of Congress, federal regulating agencies, and companies to create dialogue around the necessary steps towards a more sustainable food system. We are committed to educating consumers on the impacts of genetic engineering, GMOs, industrial agriculture and the steps that we can all take to protect and improve our food and the environment.